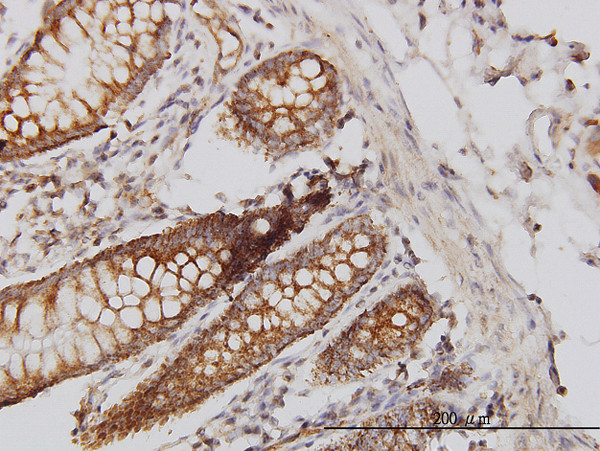
HIP1 Antibody in Immunohistochemistry (Paraffin) (IHC (P))

Search
Abnova
HIP1 Monoclonal Antibody (1F12)
{{$productOrderCtrl.translations['antibody.pdp.commerceCard.promotion.promotions']}}
{{$productOrderCtrl.translations['antibody.pdp.commerceCard.promotion.viewpromo']}}
{{$productOrderCtrl.translations['antibody.pdp.commerceCard.promotion.promocode']}}: {{promo.promoCode}} {{promo.promoTitle}} {{promo.promoDescription}}. {{$productOrderCtrl.translations['antibody.pdp.commerceCard.promotion.learnmore']}}
产品信息
H00003092-M01
宿主/亚型
分类
类型
克隆号
抗原
偶联物
形式
浓度
规格
保存条件
运输条件
产品详细信息
Sequence of this protein is as follows: DSPNLAQLQQ ASRGVNQATA GVVASTISGK SQIEETDNMD FSSMTLTQIK RQEMDSQVRV LELENELQKE RQKLGELRKK HYELAGVAEG WEEGTEASPP TLQEVVTEKE
靶标信息
Huntingtin disease, a neurodegenerate disease, is caused by the expansion of a polymorphic glutamine tract in huntingtin. The Huntingtin Interacting Protein 1 (HIP-1) is a reportedly proapoptotic, cargo-specific adaptor protein that may be involved in the pathogenesis of Huntingtin disease. As well as playing a role in Huntingtin disease, it is likely to be involved in the recruitment of clathrin coats to lipid membranes and it may also factor in tumorigenesis by allowing the survival of precancerous and cancerous cells. Since HIP-1 expression is significantly associated with prostate and colon cancer metastasis, HIP-1 can serve as a putative prognostic factor for prostate and colon cancers.
仅用于科研。不用于诊断过程。未经明确授权不得转售。